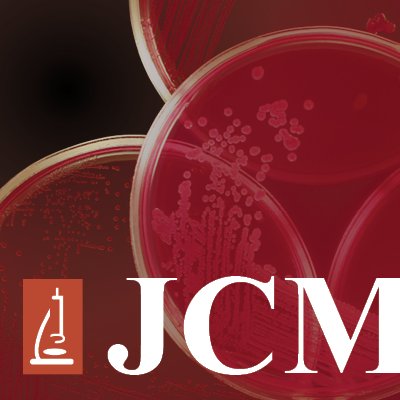

The Journal of Clinical Microbiology, led by Editor-in-Chief Alexander McAdam, delivers authoritative updates in clinical microbiology. With over 10,000 followers on its official Twitter, the journal actively engages the scientific community and disseminates cutting-edge research. Affiliated with the American Society for Microbiology, it stands as a key resource for professionals in the field.
The Journal of Clinical Microbiology, led by Editor-in-Chief Alexander McAdam, delivers authoritative updates in clinical microbiology. With over 10,000 followers on its official Twitter, the journal actively engages the scientific community and disseminates cutting-edge research. Affiliated with the American Society for Microbiology, it stands as a key resource for professionals in the field.